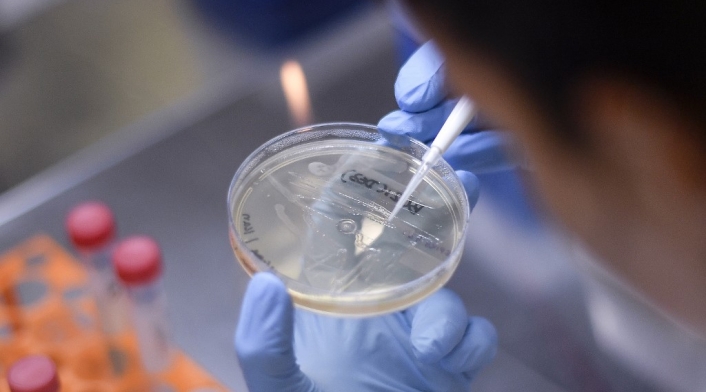

Reino Unido probará una vacuna para la COVID-19 en humanos
Las pruebas, que empezarán este jueves, están a cargo de la Universidad de Oxford.
Investigadores de la Universidad de Oxford, del Reino Unido, comenzarán a realizar pruebas de una vacuna para la COVID-19 en humanos este jueves 23 de abril, según anunció hoy el ministro de Sanidad británico, Mat Hancock.
"En tiempos normales, llegar a esta etapa habría costado años", indicó en una rueda de prensa el ministro, que recalcó que el proceso para desarrollar una vacuna es una cuestión de "prueba y error".
Le puede interesar: España extiende confinamiento con permiso de salida para niños
Pese a las incertidumbres, "las ventajas de ser el primer país del mundo que desarrolle una vacuna que tenga éxito son tan enormes que estoy poniendo todos los recursos posibles", recalcó Hancock.
El titular de Sanidad anunció que ha puesto 20 millones de libras a disposición del equipo de Oxford y otros 22 millones de libras para otro proyecto de vacuna desarrollado en el Imperial College London.
"Vamos a darles todos los recursos necesarios para maximizar las oportunidades de que tengan éxito tan pronto como sea posible", recalcó Hancock.
Mientras siguen adelante esas dos investigaciones, el Gobierno británico invertirá además para aumentar su "capacidad de manufactura", afirmó.
Lea además: Después de reducir los casos de infecciones, podremos reabrir economía: Donna Shalala
"De ese modo, si alguna de estas dos vacunas funciona y es segura, podremos hacer que esté disponible para los británicos tan pronto como sea humanamente posible", indicó el ministro.
El consejero científico del Gobierno británico, Patrick Vallance, ha advertido esta semana de que el proceso de desarrollo de una vacuna puede ser largo, incluso si muestra signos positivos de que puede proteger contra el virus.
"Todas las nuevas vacunas que comienzan a desarrollarse son proyectos a largo plazo. Solo algunas acaban teniendo éxito. Con el coronavirus no será distinto y presenta nuevos retos", advirtió.